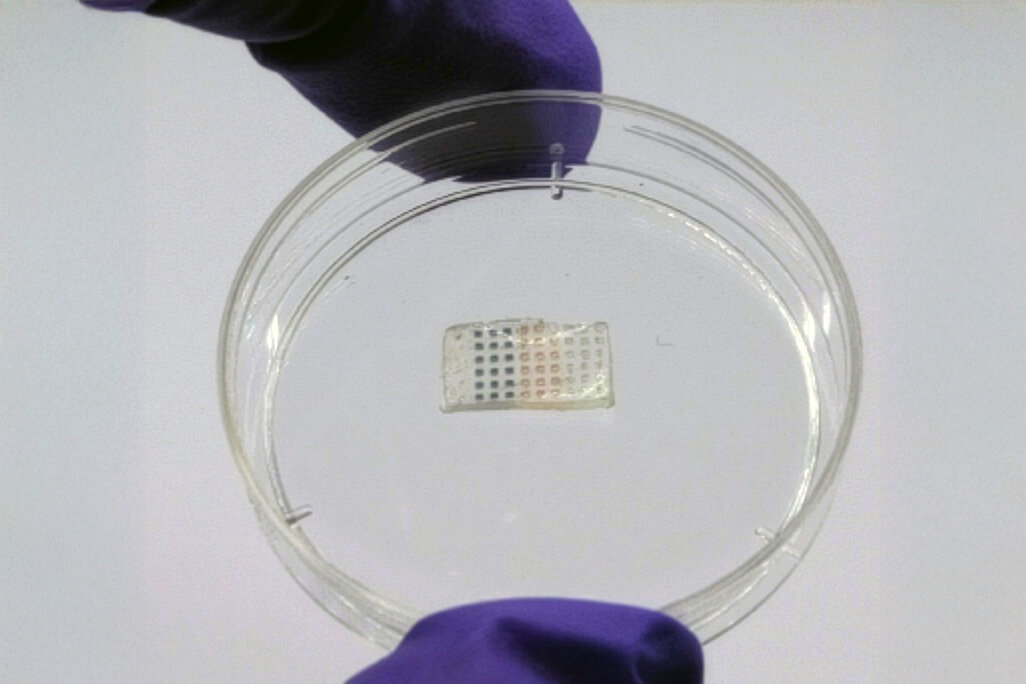
bilde av hjerteplasteret

Forskning: Nytt plaster kan hjelpe hjertet etter infarkt
Et lite plaster utviklet ved MIT kan gi nytt håp for pasienter som har hatt hjerteinfarkt. Plasteret inneholder tre typer medisiner som slippes ut i kroppen til ulike tider etter operasjonen. Foreløpig er det kun testet på rotter.
Ingeniører ved Massachusetts Institute of Technology (MIT) i USA har utviklet et medisinsk plaster som legges direkte på hjertet etter et infarkt.
– Målet vårt er å gjenopprette funksjonen og hjelpe folk med å få tilbake et sterkere og mer robust hjerte etter et hjerteinfarkt, sier forsker Ana Jaklenec i en pressemelding fra MIT.
Behandling i tre trinn
I dyreforsøk på rotter førte plasteret til 50 prosent mindre skadet vev og forbedret hjertefunksjon. Overlevelsen økte med 33 prosent sammenliknet med en kontrollgruppe som ikke fikk behandling.
Plasteret er laget av en myk hydrogel som løser seg opp i kroppen over tid. Konsistensen minner om en kontaktlinse, og plasteret er bare noen millimeter bredt. Medisinene slippes ut i tre trinn:
- først for å hindre celledød
- deretter for å lage nye blodårer
- til slutt for å motvirke arrvev
To av medisinene i plasteret er tidligere brukt i studier, men ett, GW788388, er kun testet på dyr. Forskerne planlegger videre dyreforsøk og håper på å gå videre til kliniske studier.
Kirurgisk innsetting – foreløpig
Dagens versjon av plasteret må implanteres kirurgisk. Forskerne undersøker muligheten for å bygge mikropartiklene inn i stenter som kan plasseres i arterier og frigjøre medisin etter en forhåndsprogrammert tidsplan.
















0 Kommentarer